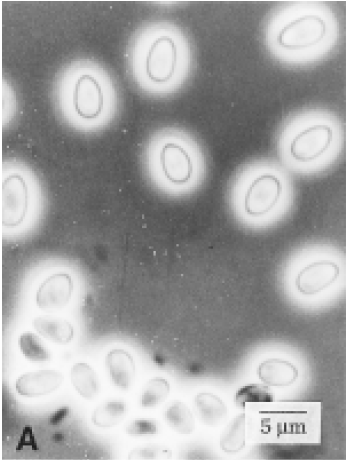
家蚕微孢子虫

家蚕微孢子虫

正版书家蚕微孢子虫基因组生物学,周泽扬主编,科学出版社
图片尺寸235x350
【绝版旧书】家蚕微孢子虫基因组生物学 科学出版社
图片尺寸800x800
家蚕微孢子虫基因组生物学 周泽扬 主编 农业基础科学专业科技 新华
图片尺寸800x800
二手书家蚕微孢子虫基因组生物学 周泽扬,潘国庆,李田 编 科学
图片尺寸700x700
家蚕微孢子虫
图片尺寸346x460
家蚕微孢子虫基因组生物学
图片尺寸1200x1600
家蚕微孢子虫nosemabombycis孢壁蛋白的研究
图片尺寸920x1302
家蚕微孢子虫基因组生物学
图片尺寸1200x1600
家蚕微孢子虫nbtom40的原核表达及定位pdf8页
图片尺寸792x1158
nyt36772020家蚕微孢子虫荧光定量pcr检测方法
图片尺寸700x993
家蚕微孢子虫nosemabombycis孢壁蛋白的研究
图片尺寸920x1302
一株家蚕异型微孢子虫感染特征和分类地位
图片尺寸242x476
家蚕微孢子虫极管蛋白1nbptp1在果蝇s2细胞中的表达与糖基化修饰
图片尺寸368x321
家蚕微孢子虫极管蛋白1nbptp1在果蝇s2细胞中的表达与糖基化修饰
图片尺寸414x213
基于crispr/cas12a系统的家蚕微孢子虫可视化检测方法及其试剂盒
图片尺寸1733x1346
引用lamp技术检测家蚕微孢子虫孢子的试验_参考网
图片尺寸1937x676
家蚕微孢子虫基因组生物学
图片尺寸4627x3000
昆虫微孢子虫对家蚕的感染力及其增殖情况研究
图片尺寸640x480
cn105154576a_快速检测家蚕微孢子虫的引物对及其试剂盒和检测方法在
图片尺寸810x1000
微孢子虫的起源进化及pcr快速检测家蚕微粒子病.pdf
图片尺寸793x1120